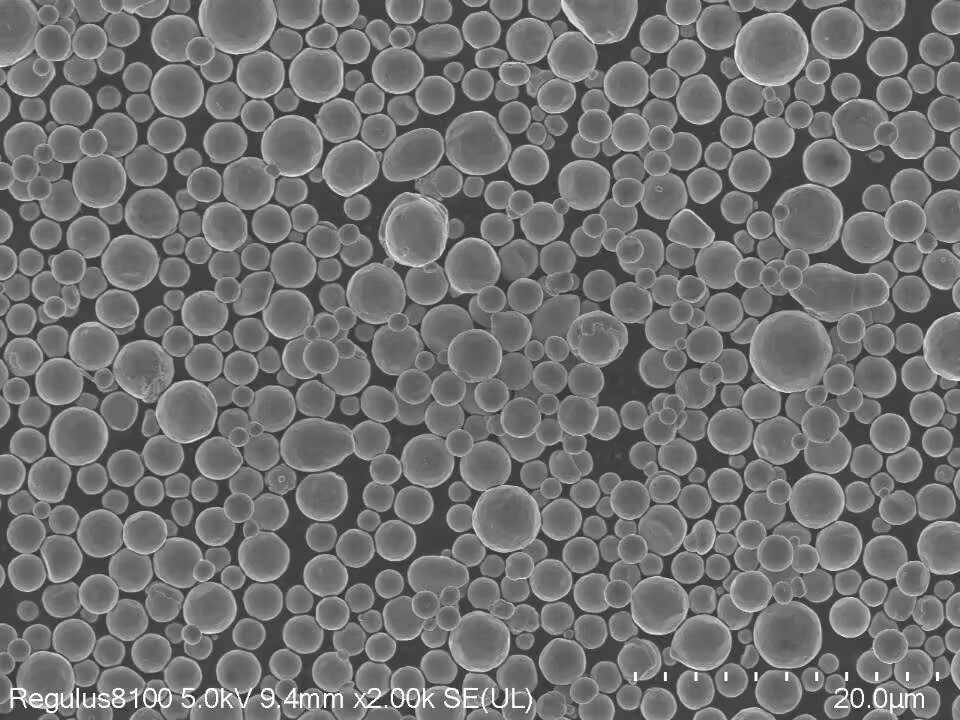

光伏浆料从减银到无银,导电粉体如何选择
光伏浆料从减银到无银,导电粉体如何选择
2025 年全球光伏装机量即将冲破 500GW 大关,清洁能源转型正加速向前狂奔,但一条隐形的资源枷锁却悄然收紧——白银,这个光伏电池金属化环节的核心材料,正成为制约行业降本增效的关键瓶颈。
从减银到代银,光伏产业链早已打响这场去银战役。但以铜代银从来不是简单的材料替换。铜在高温下易氧化形成绝缘层,原子扩散还会导致电池失效,而银包铜粉的银含量控制、抗氧化性与工艺适配性,更成为浆料企业的核心技术痛点。
早在光伏少银化浪潮初起时,安特普纳便瞄准铜基材料赛道,深度参与光伏浆料从银依赖到铜主导的技术转型。依托对光伏工艺的深刻理解,我们推荐低银含量银包铜粉、多规格铜粉及镍粉产品,精准匹配银包铜浆料、纯铜浆等多条技术路线需求,为行业提供从减银到无银的导电粉体材料支撑。

低银含量银包铜粉
10%球状银包铜粉AC-N

8%球状银包铜粉AC-3

纳米、亚微米铜粉
多规格纳米、亚微米铜粉的技术参数:

微米铜粉
多规格微米铜粉的技术参数:

镍粉
D50:3微米球形镍粉
规格参数:

电镜照片:
粒径分布图:

D50:5.0-5.5微米球形镍粉
粒径分布图:

D50:6.0-6.5微米球形镍粉
粒径分布图:

安特普纳公司积极布局太阳能光伏行业,全力助力中国智造,为光伏浆料领域提供性能优异的低银含量银包铜粉,纳米/亚微米铜粉,微米铜粉,微米镍粉。